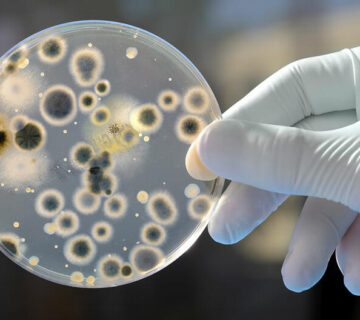

À propos
À la demande d’une coopérative locale, LA2E a effectué des analyses physico-chimiques et microbiologiques sur plusieurs lots de beurre de karité destinés à l’exportation. L’objectif était de s’assurer que les produits respectaient les normes internationales (absence de contaminants, taux d’acide gras, pureté, etc.). Ce projet a renforcé la crédibilité des produits à l’export et permis à la coopérative d’obtenir de nouveaux marchés.
LA2E
Spécialiste en
Analyse qualité et sécurité des produits cosmétiques

No comment